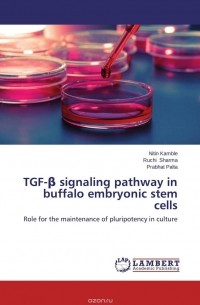

Nitin Kamble — новинки
-
TGF-? signaling pathway in buffalo embryonic stem cells Nitin Kamble, Ruchi Sharma, Prabhat Palta
ISBN: 9783659555756 Год издания: 2014 Издательство: LAP LAMBERT Academic Publishing Язык: Английский ES cells have very many varied applications for farm animals as well as humans, like enabling studies on the fundamental events in embryonic development, production of therapeutic delivery systems, gene targeting, and regenerative medicine. Production of pluripotent ES cells from farm animal species will have a big influence on the genetic modification of these animal species. Availability of ES cells is expected to be especially useful in cloning technology. Also, in the context of gene targeting, use of ES cells could overcome current limitation on efficient gene transfer by providing an abundance of stem cells to be genetically manipulated by using conventional recombinant DNA techniques. Very limited information is available on the signaling pathways that govern the self renewal of ES cells while maintaining them in an undifferentiated and pluripotent state. Among other important regulators, members of the transforming growth factor-? (TGF-?) super-family. -
Metal toxicity on neurocytes and gill of bivalve L. corrianus Nitin Kamble, Sunil Londhe
ISBN: 9783659450891 Год издания: 2013 Издательство: LAP LAMBERT Academic Publishing Язык: Английский Industrial and agricultural development has put new challenges before investigators in the field of toxicology. Metal contamination in aquatic ecosystem severely affected biological and economical important flora and fauna, molluscs are one of them. Present study is focused on comparative effect of Hg, Zn and Co to the freshwater bivalve Lamellidens corrianus. Neuronal cells and different cells of gills were intoxicated in maintained laboratory conditions. Results showed significant structural alterations in the neurocytes of cerebral ganglia and gills. The physiological activities as oxygen consumption, behavior and bioaccumulation rate were investigated. Hg showed more prominent toxic effects as compared to induction of Zn and Co. Co were least toxic among the induced heavy metals. Present study will be helpful for further toxicological investigation, control mechanism in relation to biodiversity and sustainable development of molluscan fauna for to maintain balance of food chain in the ecosystem.